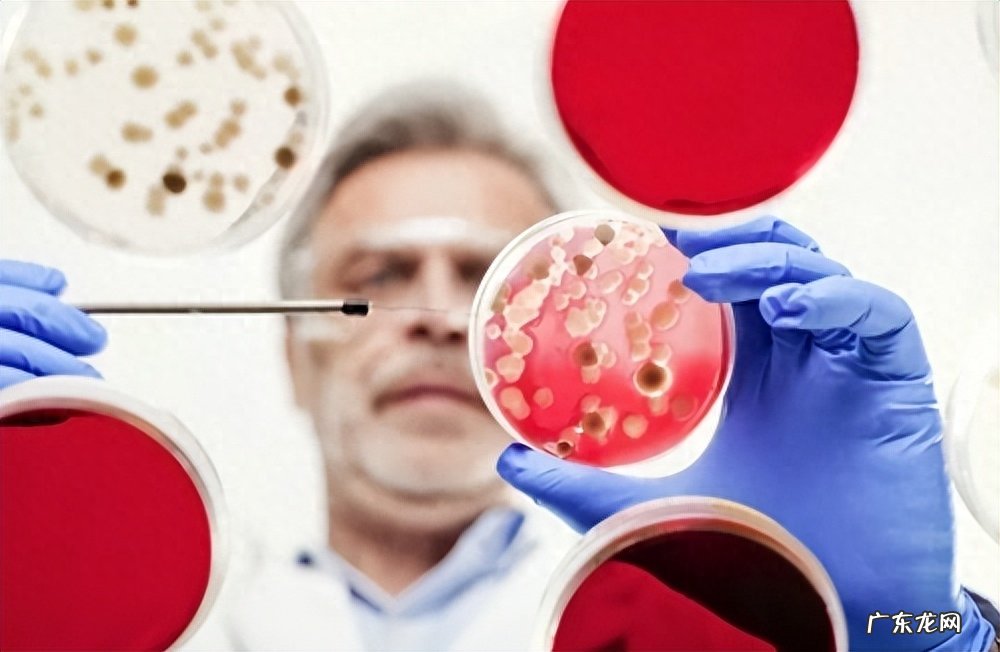

前言
当代社会,对于男性性能力的讨论一直都是存在的,尤其是那个关于“一夜七次”的传闻 。然而,在我们深入探讨这个话题之前,有必要以专业的视角来审视这个问题,借助科学数据和医学观点,揭示其中的真相 。
文章插图
性生活是人类生活中不可或缺的一部分,不仅关乎情感的交流,也涉及到身体健康 。随着信息的传播速度不断加快 , 各种关于性能力的传闻也在社交媒体和口耳相传中迅速传播开来 。其中最引人注目的莫过于“一夜七次”的说法,这似乎是一种性能力的象征,让人们为之侧目 。
然而 , 我们必须理性地审视这个问题,以免受到夸张和虚假信息的误导 。在现代社会 , 性生活的观念已经越来越开放,但同时也需要以科学的态度对待,免除对性生活的过度追求 。在追求快感和满足的同时,我们也应该关注身体的健康和情感的共鸣 。
因此,我们将从专业角度出发 , 以科学的数据和医学的观点,来解析“一夜七次”这个话题背后的真实情况 。我们将具体了解身体状况与个体差异、生理极限与健康风险,以及情感和心理因素对性能力的影响,揭示性生活的现实与“神话”之间的关系 。
现在,让我们一起了解一下男性的身体状况和个体差异 , 看看是什么让每个“战士”在性战场上表现不同 。
想象一下,性活动就像一场紧张的运动比赛 。就像参与体育锻炼的人一样,拥有健康的肌肉和良好的体能可能会在性生活中具备一些优势 。那些经常锻炼的“肌肉战士”可能在耐力和持久力方面表现得更好,而有时过多的脂肪可能会使“脂肪勇士”在这场比赛中感到吃力 。

文章插图
图片来源网络
年龄也是一个关键因素 。年轻的“快兵”通常拥有更高的能量水平和较快的恢复能力,使他们在性活动中表现活力四射 。
然而,与此同时,有些“老将”可能在技巧和经验方面胜过年轻人,虽然可能不再追求“一夜七次”的壮举 , 但他们懂得如何在有限的时间内取得最大的满足 。
荷尔蒙水平在男性性能力中发挥着重要作用 。那些拥有高睾酮水平的“睾酮小将”可能会拥有更强的性欲和活力,但同时也需要警惕睾酮水平的突然下降 。与此相对 , “荷尔蒙军团”可能会在不同的时间段表现出不同的性欲,取决于他们荷尔蒙的变化 。
不同的“战士”在性生活的战场上都有各自的特点和优劣势 。然而,重要的是要意识到,性活动不仅仅是身体的竞争,更是情感的交流和心理的愉悦 。
尽管“一夜七次”可能在一些案例中是可行的 , 但绝大多数情况下,过度的性活动可能对身体和心理健康造成负面影响 。
在性生活的战场上 , 每个“战士”都渴望展现自己最强大的一面,但我们必须认识到,这场战斗可能不仅涉及愉悦 , 还可能伴随着生理极限和健康风险 。
性活动让身体充满了活力,就像战士冲锋陷阵一样 。但想想那种感觉,战士从战场回来后精疲力尽,每一次性行为也是一次激烈的体力消耗 。过度的性活动可能让“战士”在生活中感到疲倦 , 需要更多时间来恢复 。
就像在战场上,心脏承载着士兵的希望和勇气 。在性活动中,心脏也经历着激情和加速的律动 。然而,频繁的性活动可能让心脏承受过多负荷 , 就像一个需要不断战斗的士兵一样 , 需要适时的休息和恢复 。
- 生字不认识的字怎么查读音
- 胖五低温的极限是多少 “胖五”低温的极限是多少
- 上火了还能吃柚子吗 柚子吃了会上火吗
- 如何在电脑中使用”任务计划“
- 一山二虎是什么意思 二虎是什么意思
- 黑米怎么蒸米饭 黑米怎么粥煮好吃
- 五观是什么 五官是什么
- 医生提醒:长期睡前玩手机的人,小心这八个“痛苦”落在你身上
- 山西大姐与“伴侣”旅行被迷晕,接连灌她催情药后,一发不可收拾
- “硼砂猪肉”已泛滥?强烈建议不要吃,如何挑选好猪肉,一文说清
特别声明:本站内容均来自网友提供或互联网,仅供参考,请勿用于商业和其他非法用途。如果侵犯了您的权益请与我们联系,我们将在24小时内删除。
